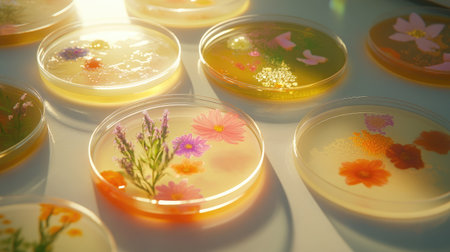
Several Petri dishes with different microorganism cultures on a lab table, capturing diversity in microbial growth and research.の素材

素材 - Several Petri dishes with different microorganism cultures on a lab table, capturing diversity in microbial growth and research.
作品情報
Several Petri dishes with different microorganism cultures on a lab table, capturing diversity in microbial growth and research.
- ID:258803427
- 作品種別:
- 作者名:suphauarrn Manosri
キーワード
- adult
- analysis
- background
- bacterium
- bio
- biochemistry
- biodiversity
- biological
- biology
- biotechnology
- chemist
- circle
- clinical
- close
- colony
- contaminated
- contamination
- copy space
- culture
- cultures
- different
- dirty
- disease
- dish
- disinfect
- experiment
- genetic
- germ
- grow
- growth
- health
- hygiene
- infection
- infectious
- laboratory
- macro
- medicine
- micro
- microbe
- microbiology
- mobile phone
- organism
- plate
- research
- science
- scientific
- technology
類似作品
Collage of diff...
Flat-lay of hea...
A congested sin...
Lush Vegetarian...
A person scoopi...
Friends enjoyin...
a top view flat...
set of pasta at...
A street food v...
Delicious Delig...
A wooden table ...
A delicious bre...
Fresh Gourmet F...
A beautiful arr...
Indulge your se...
Black Spaghetti...
lots of dirty w...
View from above...
Italian cuisine...
A colorful arra...
Traditional Kor...
A man is cookin...
A table with ma...
Traditional Tur...
Chef plating a ...
Woman at the ta...
A view of weddi...
Eid Mubarak Mus...
A colorful asso...
baked eggplants...
A chef tossing ...
Set of differen...
Stunning modern...
Variety of pub ...
Chefs preparing...
A lavish table ...
Men Drinking Be...
Traditional Tur...
High angle view...
many empty whit...
asian food set ...
Help with feedi...
Joyful office H...
A close-up of a...
Dining with fri...
Rich and delici...
A vibrant sprea...
freshly prepare...